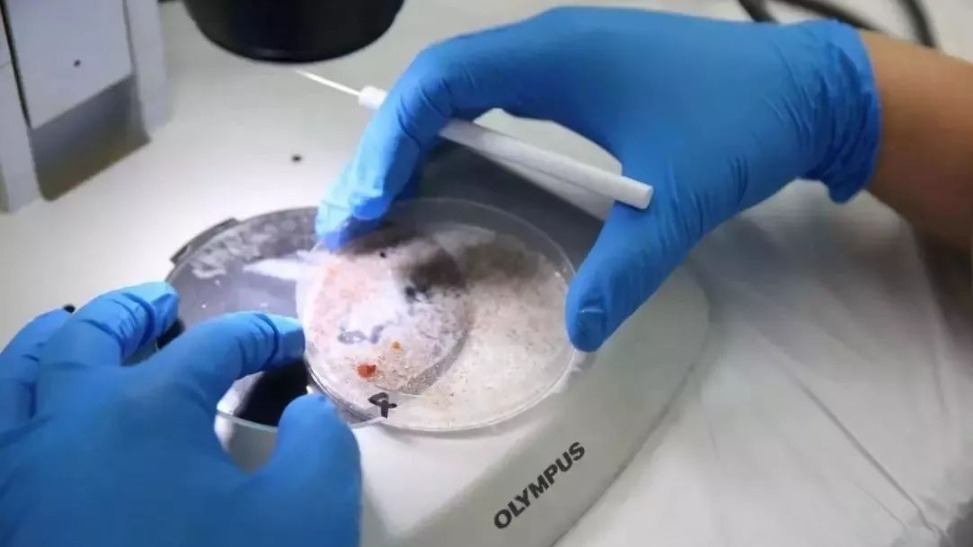
天津出现肺吸虫病例,多人死亡?官方辟谣_凤凰网

大平肺吸虫(おおひらはいきゅうちゅう、学名:Paragonimus ohirai)とは、肺吸虫科 Paragonimus 属に属する吸虫の1種であり寄生虫。虫卵は左右対称で、一端に小蓋を有し、他端に小突起を有する。
第一中間宿主は大河川の河口の汽水域の干潟の汀線より上の塩性湿地の泥の上に生息するカワザンショウ科の微小な巻貝であるムシヤドリカワザンショウ(Assiminea parasitologica)とヨシダカワザンショウ(A. yoshidayukioi)、サツマクリイロカワザンショウ(Angustassiminea nitida)が記録されており、実験的にはミヤイリガイにもよく感染する、第二中間宿主はやはり汽水域のカニであるクロベンケイガニとベンケイガニの2種の感染率が高く、他に近縁なアカテガニ、アシハラガニ、ハマガニなどにも感染する。終宿主はドブネズミ、イヌ、タヌキ、イタチ、イノシシ、ブタなど。虫卵は終宿主の肺から喀痰と共に排出されて気管、消化管を経て糞便とともに排出、あるいは口から喀痰とともに排出される。虫卵は水中で発育してミラシジウムとなり、ミラシジウムは第一中間宿主であるカワザンショウ科の巻貝の体表から侵入し、体内でスポロシストに変態。スポロシストは体内の胚細胞が発育したレジアを産み、レジアは同様にセルカリアを産む。汽水域の干潟の泥上に生息する第一中間宿主が降雨などで水に浸されると体内からセルカリアが脱出して第二中間宿主であるカニの関節部の体表から侵入することで体内へ移行し、セルカリアからメタセルカリアへと発育する。終宿主がカニ類を摂取することにより終宿主の小腸へ移行し、小腸で脱嚢、腹壁を穿孔して胸腔をへて肺に移動し、ペアを形成して虫嚢を作る。
ヒトで成虫が肺に寄生を完了した確実な例は知られていないが、幼生が皮下に感染したと思しき症例、イノシシの生肉を食べた後に胸水の貯留と好酸球数の著しい増加がみられて血清学的に大平肺吸虫の寄生例ではないかと疑われた症例が知られている。
分布域は日本国内では熊本県、鹿児島県、宮崎県、三重県、兵庫県、千葉県、石川県、愛知県、静岡県、京都府、高知県の各県の大河川の河口付近が知られており、国外では揚子江河口にみられる。
脚注
参考文献
- 吉田幸雄 (1991) 図説人体寄生虫学, 南山堂, 東京 ISBN 978-4-525-17024-0
- 今井壯一ほか編 『最新家畜寄生虫病学』 朝倉書店 2007年 ISBN 4254460279
関連項目
- 肺吸虫症
![【寄生虫】大平肺吸虫 成虫 [Parasite, Adult of the Paragonimus oohira] YouTube](https://i.ytimg.com/vi/fjR43axtiMk/maxresdefault.jpg)